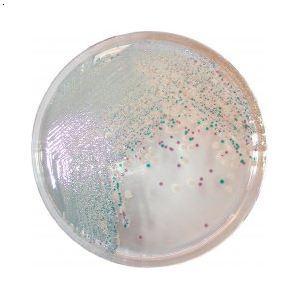

弯曲菌是一种常见的导致人类肠炎的致病菌,以腹泻为主要特征,并可从粪便中分离出来。
ISO于2017年发布了新版的ISO10272-1:2017标准,即《食品链的微生物学,弯曲菌属检测和计数的水平方法》。其中建议的弯曲菌检测方案,依据样本类型和检测目的,分为三种:1)在弯曲菌多的时候,不需要增菌,用方案C;2)对于弯曲菌和背景菌都较少的情况,用方案A,例如烹制过的或低温食品。取样后再Bolton肉汤微需氧37℃先培养4-6h,再41.5℃培养44h±4h;3)对于弯曲菌少,背景菌多的情况,例如生肉、生乳,采用方案B,在Preston肉汤中微需氧41.5℃培养24h±2h。
增菌后,方案A是采用mCCD琼脂和另一款其选择剂不同于mCCD的弯曲菌选择分离培养基来分离,方案B是采用mCCD琼脂来分离。均为微需氧41.5℃培养44h±4h。在mCCD琼脂上弯曲菌典型菌落为灰色。对于ISO10272-1:2017中方案A所提到的另一款其选择剂不同于mCCD的弯曲菌选择分离培养基,可选择HiCrome弯曲菌显色培养基(厂家:HiMedia,货号M2020,配合弯曲菌选择性添加剂(货号FD178)一起使用)。该显色培养基含有复合蛋白胨、氯化钠、多种显色剂、生长因子和琼脂。适用于食品样本和临床样本。培养基配好为在平皿中为黄色透明至轻微不透明凝胶。35-37℃孵育24-48小时后,弯曲菌菌落为淡紫色(下图),回收率≥50%。而金葡菌和大肠埃希菌均被抑制。
传统的弯曲菌培养基,是使用改良的黑色活性炭头孢哌酮脱氧胆酸琼脂(mCCDA)。但弯曲菌菌落在黑色的培养基上为无色,通常很难检测到。而HiCrome弯曲菌显色培养基在mCCDA培养基基础上研发出来,其鉴别能力显著优于mCCDA培养基。